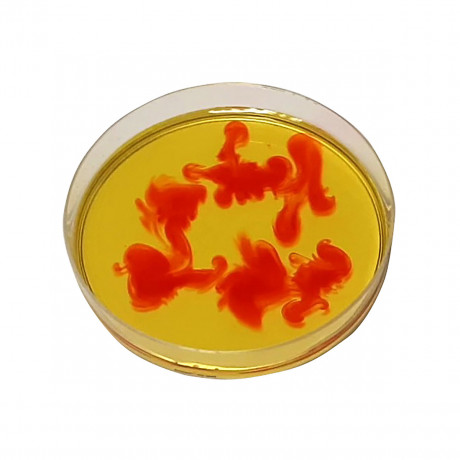
myExperimentSet FORSCHER ИССЛЕДОВАТЕЛИ

myExperimentSet FORSCHER ИССЛЕДОВАТЕЛИ
myExperimentSet FORSCHER ИССЛЕДОВАТЕЛИ
Бренд:
myExperimentSetКОРОБКА НА ДЕНЬ РОЖДЕНИЯ: Насыщенные цвета (на 12 детей)
Характеристики
Вес отправления:
1500 г
Возрастная рекомендация:
от 6 до 10 лет
Тип товара:
Коллективные игры
Цвет:
разноцветный
Бренд:
myExperimentSet
Категории
✔ Бесплатная доставка Пункт выдачи САНКТ-ПЕТЕРБУРГ, Лиговский проспект 74, Самовывоз
Избранное
Сравнение
Описание
Рекомендуемый возраст: от 6 до 10 лет
С коробкой ко дню рождения «Цвета и плотность для юных исследователей» от myExperimentSet можно провести 6 разных экспериментов, 4 дополнительных варианта эксперимента и 3 поделки на тему цветов и плотности. Экспериментальная программа длится не менее 2 часов.
Подробные инструкции по проведению экспериментов с множеством изображений и соответствующих возрасту, но научно обоснованных объяснений ведут через эксперименты. Коробка на день рождения доступна в трех размерах для 8, 10 и 12 детей.
Юные исследователи
• узнать, что плавает, плавает или тонет
• исследовать, "плавают" ли жидкости; может
• экспериментируйте с разноцветными каплями
• позволять появляться новым цветам
• создать свою собственную радугу
• сделать красочную бабочку
ОБЪЕМ ПОСТАВКИ:
- Ламинированные водолазы и дельфины
- Пробки, ершики, зубочистки
- гайки, шайбы, гвозди
- Пипетки, круглые фильтры, мензурки, деревянные прищепки
- Подставки для отверстий, карандаши, уплотнительные кольца,
- Чашки Петри, пробирки, бумажные соломинки, 4 разных пищевых красителя
- Шаблоны волчка
- Приглашения для пробирок, подарочные пакеты
- 8-страничные иллюстрированные инструкции с понятными для детей, но научными объяснениями
Наборы myExperimentSets разработаны и совершенствуются инструкторами курсов «FR?HES FORSCHEN», которая вот уже 20 лет предлагает экспериментальные курсы для детей в школах и детских садах по всей Германии.
Дополнительная информация
• Набор содержит все специальные материалы, необходимые для экспериментов.
• Хозяйственные принадлежности и необходимые продукты в комплект не входят.
• Кроме того, у каждого ребенка есть приглашение в пробирке и сумка для перевозки сувениров исследователя.
• Опасность! В силу своей функции отдельные части имеют острые кончики и края. Риск получения травмы!
• Инструкции супервайзера прилагаются и должны соблюдаться. Сохраняйте упаковку и инструкцию, так как они содержат важную информацию! Технические изменения защищены.
Характеристики
Вес отправления | 1500 г |
Возрастная рекомендация | от 6 до 10 лет |
Тип товара | Коллективные игры |
Цвет | разноцветный |
Бренд | myExperimentSet |